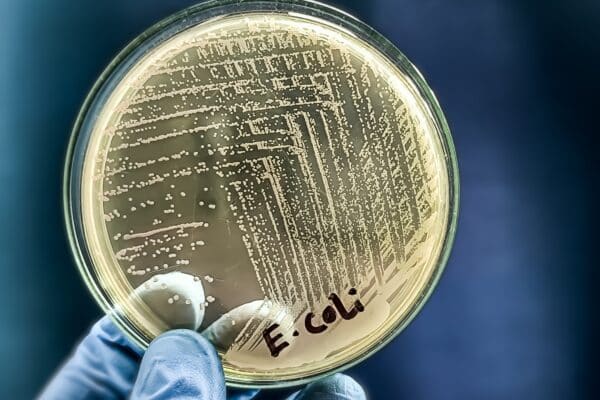
A microbiological culture Petri dish with a colonies of the pathogenic bacterium Escherichia coli (E. coli)

Home › Archives for StudyFinds Analysis › Page 139
StudyFinds Analysis
Called "brilliant," "fantastic," and "spot on" by scientists and researchers, our acclaimed StudyFinds Analysis articles are created using an exclusive AI-based model with complete human oversight by the StudyFinds Editorial Team. For these articles, we use an unparalleled LLM process across multiple systems to analyze entire journal papers, extract data, and create accurate, accessible content. Our writing and editing team proofreads and polishes each and every article before publishing. With recent studies showing that artificial intelligence can interpret scientific research as well as (or even better) than field experts and specialists, StudyFinds was among the earliest to adopt and test this technology before approving its widespread use on our site. We stand by our practice and continuously update our processes to ensure the very highest level of accuracy. Read our AI Policy (link below) for more information.
As Seen On








©2026 StudyFinds. All rights reserved. Privacy Policy • Disclosure Policy • Do Not Sell My Personal Information